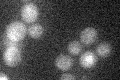
YDL227C
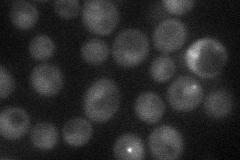
YDL227C

View description
Site-specific endonuclease required for gene conversion at the MAT locus (homothallic switching) through the generation of a ds DNA break; expression restricted to mother cells in late G1 as controlled by Swi4p-Swi6p, Swi5p and Ash1p
Localization:
Intensity:
Fold change:
Significance:
-
C’ GFP library in SD
below threshold16.03 -
N' NOP1pr-GFP in SD
punctate,nucleus27.0842 -
N' TEF2pr-mCherry in SD

below threshold6.14331 -
N' NATIVEpr-GFP in SD

cytosol20.0759 -
N' TEF2pr-VC and Cyto-VN in SD

#N/A0 -
C’ GFP library in SD+DTT

cytosol15.840.98No -
C’ GFP library in SD+H2O2

cytosol16.871.05No -
C’ GFP library in Starvation Media

cytosol16.121No -
C’ GFP library on the background of Pup2-DaMP

below threshold -
C’ GFP library on the background of CCT mutant

below threshold17.97541.12081No
